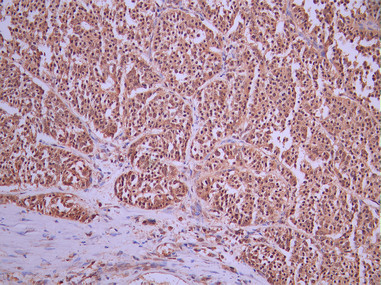

PSMD14 Recombinant Monoclonal Antibody
-
中文名稱:PSMD14 Recombinant Monoclonal Antibody
-
貨號:CSB-RA886270A0HU
-
規格:¥1320
-
圖片:
-
Western Blot
Positive WB detected in: MCF7 whole cell lysate(30μg), K562 whole cell lysate(30μg), U251 whole cell lysate(30μg), SH-SY5Y whole cell lysate(30μg), Jurkat whole cell lysate(30μg), COLO205 whole cell lysate(30μg), Mouse stomach tissue lysate(30μg), Rat stomach tissue lysate(30μg)
All lanes:PSMD14 antibody at 1:1000
Secondary
Goat polyclonal to rabbit IgG at 1/40000 dilution
Predicted band size: 35 kDa
Observed band size: 35 kDa
Exposure time:1min -
IHC image of CSB-RA886270A0HU diluted at 1:100 and staining in paraffin-embedded human liver cancer performed on a Leica BondTM system. After dewaxing and hydration, antigen retrieval was mediated by high pressure in a citrate buffer (pH 6.0). Section was blocked with 10% normal goat serum 30min at RT. Then primary antibody (1% BSA) was incubated at 4°C overnight. The primary is detected by a Goat anti-rabbit polymer IgG labeled by HRP and visualized using 0.05% DAB.
-
Immunofluorescence staining of PC-3 cell with CSB-RA886270A0HU at 1:50 , counter-stained with DAPI. The cells were fixed in 4% formaldehyde, permeabilized using 0.2% Triton X-100 and blocked in 10% normal Goat Serum. The cells were then incubated with the antibody overnight at 4°C. The secondary antibody was Alexa Fluor 488-congugated AffiniPure Goat Anti-Rabbit IgG(H+L).
-
Overlay Peak curve showing 786-O cells stained with CSB-RA886270A0HU (red line) at 1:100. The cells were fixed in 4% formaldehyde and permeated by 0.2% TritonX-100 for 10min. Then 10% normal goat serum to block non-specific protein-protein interactions followed by the antibody (1ug/1*106cells) for 45min at 4℃. The secondary antibody used was FITC-conjugated goat anti-rabbit IgG (H+L) at 1/200 dilution for 35min at 4℃.Control antibody (green line) was Rabbit IgG (1ug/1*106cells) used under the same conditions. Acquisition of >10, 000 events was performed.
-
-
其他:
產品詳情
-
Uniprot No.:
-
基因名:PSMD14
-
別名:26S proteasome non-ATPase regulatory subunit 14 antibody; 26S proteasome regulatory subunit rpn11 antibody; 26S proteasome-associated PAD1 homolog 1 antibody; 26S proteasome-associated PAD1 homolog antibody; PAD1 antibody; PAD1, yeast, homolog of antibody; POH1 antibody; Proteasome (prosome, macropain) 26S subunit, non-ATPase, 14 antibody; Proteasome 26S subunit non ATPase 14 antibody; PSDE_HUMAN antibody; Psmd14 antibody; RPN11 antibody; Testis tissue sperm binding protein Li 69n antibody
-
反應種屬:Human, Mouse, Rat
-
免疫原:A synthesized peptide from human PSMD14 protein
-
免疫原種屬:Homo sapiens (Human)
-
標記方式:Non-conjugated
-
克隆類型:Monoclonal
-
抗體亞型:Rabbit IgG
-
純化方式:Affinity-chromatography
-
克隆號:25G9
-
濃度:It differs from different batches. Please contact us to confirm it.
-
保存緩沖液:Rabbit IgG in 10mM phosphate buffered saline , pH 7.4, 150mM sodium chloride, 0.05% BSA, 0.02% sodium azide and 50% glycerol.
-
產品提供形式:Liquid
-
應用范圍:ELISA, WB, IHC, IF, FC
-
推薦稀釋比:
Application Recommended Dilution WB 1:500-1:5000 IHC 1:50-1:200 IF 1:50-1:200 FC 1:50-1:200 -
Protocols:
-
儲存條件:Upon receipt, store at -20°C or -80°C. Avoid repeated freeze.
-
貨期:Basically, we can dispatch the products out in 1-3 working days after receiving your orders. Delivery time maybe differs from different purchasing way or location, please kindly consult your local distributors for specific delivery time.
-
用途:For Research Use Only. Not for use in diagnostic or therapeutic procedures.
相關產品
靶點詳情
-
功能:Component of the 26S proteasome, a multiprotein complex involved in the ATP-dependent degradation of ubiquitinated proteins. This complex plays a key role in the maintenance of protein homeostasis by removing misfolded or damaged proteins, which could impair cellular functions, and by removing proteins whose functions are no longer required. Therefore, the proteasome participates in numerous cellular processes, including cell cycle progression, apoptosis, or DNA damage repair. The PSMD14 subunit is a metalloprotease that specifically cleaves 'Lys-63'-linked polyubiquitin chains within the complex. Plays a role in response to double-strand breaks (DSBs): acts as a regulator of non-homologous end joining (NHEJ) by cleaving 'Lys-63'-linked polyubiquitin, thereby promoting retention of JMJD2A/KDM4A on chromatin and restricting TP53BP1 accumulation. Also involved in homologous recombination repair by promoting RAD51 loading.
-
基因功能參考文獻:
- overexpression of RPN11 in breast cancer tissues was associated with an advanced clinical stage. Patients with tumors with high expression of RPN11 had worse prognosis. PMID: 28535005
- Deubiquitylase POH1 stabilizes E2F1 protein through binding to and deubiquitylating E2F1 in liver cancer. PMID: 26510456
- The data demonstrated that proteasomal POH1 is a key de-ubiquitinating enzyme that regulates ubiquitin conjugates generated in response to damage and that several aspects of the DNA double-strand break response are regulated by the proteasome. PMID: 22909820
- Disorder of POH1 expression is involved in the onset of idiopathic nephrotic syndrome (INS), and confers multidrug resistance in children with INS PMID: 19419512
- Down-regulation of PSMD14 results in decreased cell proliferation, cell cycle arrest and senescence. A comparative study with PSMB5, revealed that PSMB5 and PSMD14 have different effects on cell cycle, senescence and associated molecular events. PMID: 19732767
- Ectopic expression of POH1 in HEK293 cells decreased the level of c-Jun ubiquitination, leading to significant accumulation of the protein and a corresponding increase in AP1-mediated gene expression PMID: 16569633
- An intact zinc metalloproteinase motif of Poh1 is essential for cell viability and 26S proteasome function. PMID: 17237285
- Specificity for K63-linked polyubiquitin is a common property of the JAMM/MPN+ family of deubiquitinating enzymes. PMID: 19214193
顯示更多
收起更多
-
蛋白家族:Peptidase M67A family, PSMD14 subfamily
-
組織特異性:Widely expressed. Highest levels in heart and skeletal muscle.
-
數據庫鏈接:
Most popular with customers
-
YWHAB Recombinant Monoclonal Antibody
Applications: ELISA, WB, IHC, IF, FC
Species Reactivity: Human, Mouse, Rat
-
Phospho-YAP1 (S127) Recombinant Monoclonal Antibody
Applications: ELISA, WB, IHC
Species Reactivity: Human
-
-
-
-
-
-